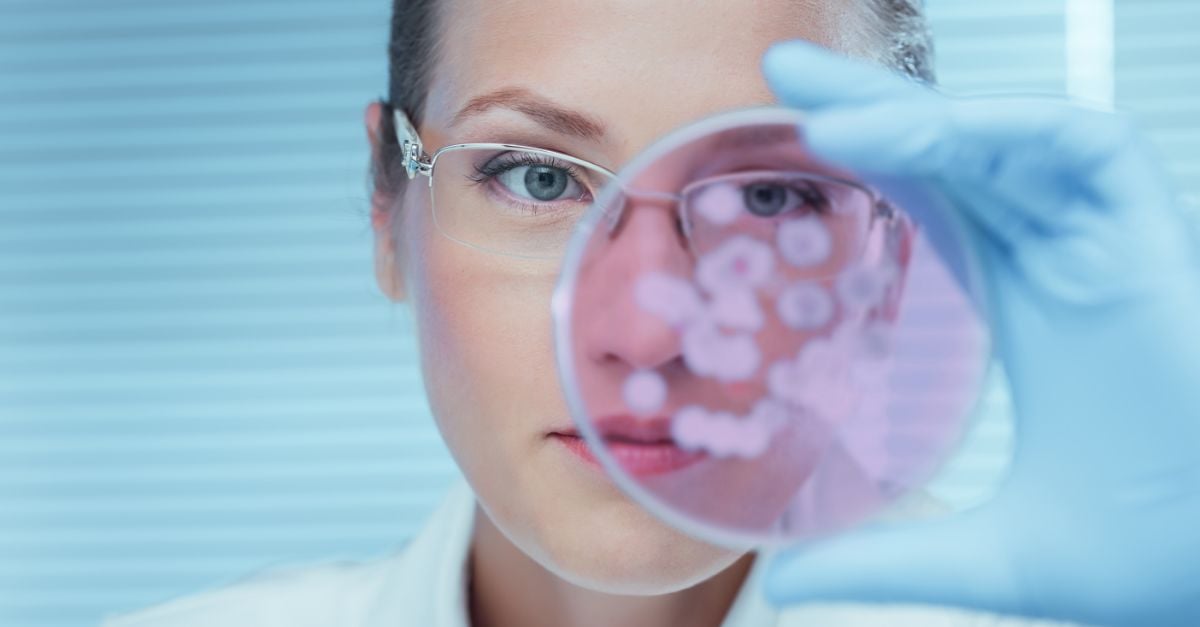

Notre histoire
Aux côtés des laboratoires depuis plus de 45 ans
Une véritable expertise du secteur
Notre gamme de solutions logicielles pour les laboratoires s’étend des laboratoires de santé, de santé publique, des services contractuels, de la toxicologie, traitant de la qualité de l’eau, de l’environnement, d’agro-alimentaire, des boissons, et des sciences de la vie. Dans le futur, nous étendrons notre offre aux secteurs de la biotechnologie et de la pharmacie.
Pourquoi nous faisons la différence
45+
années d’expertise en informatique de laboratoire
24%
de laboratoires cliniques dans le monde utilisent nos systèmes d’information
1,450
Collaborateurs, spécialistes de l’informatique de laboratoire et de la santé répartis dans 12 pays
Clinisys : Une Histoire de Fiabilité et d’Expertise
Depuis la fondation de Sunquest en 1979, Clinisys a su se positionner comme un leader mondial de l’informatique de laboratoire. Basée à Tucson, (USA) notre entreprise dispose également de bureaux à Paris (France), Gent (Belgique), Orihuela (Espagne), Walluf (Allemagne), Woking (UK) et Raleigh (USA). Grâce à des acquisitions et des fusions stratégiques, nous détenons aujourd’hui une part de marché mondiale d’environ 24 %, selon Signify Research : Laboratory Information Systems – World, 2025. Notre succès repose sur la fiabilité et l’expertise de nos équipes.
Depuis notre création, nos équipes sont composées de véritables spécialistes du laboratoire qui comprennent votre quotidien et qui ont profité des connaissances acquises dans les laboratoires pour enrichir et développer nos solutions.
Aujourd’hui, ce sont plus de 4 000 laboratoires à travers le monde qui nous font confiance pour optimiser leurs flux de travail et améliorer l’efficacité de leurs équipes et la productivité de leur laboratoire.

1890 : Découvrez l’histoire fascinante de Roper Technologies
La société mère de Clinisys, fondée en 1890 par George D. Roper, a débuté comme fabricant d’appareils ménagers, de pompes et de produits industriels. Aujourd’hui, Roper Technologies est un acteur majeur, faisant partie du Nasdaq 100, du S&P 500 et du Fortune 1000.

1979 : Fondation de Sunquest Information Systems
Sunquest, notre ancienne société sœur sous Roper Technologies avant notre fusion en 2022, a été fondée par les ingénieurs Jim Peebles et Bob Morrison, ainsi que le pathologiste Dr Sidney Goldblatt. Sunquest a installé son premier laboratoire deux ans plus tard, en 1981.

1987 : Création de HORIZON LIMS
Horizon LIMS a été fondée en 1987 et rachetée par Roper Technologies en 2022. Elle était à l’origine connue sous le nom de Chemware. HORIZON a déployé son premier LIMS en 1991 et un LIMS version cloud en 2016.

1988 : Une nouvelle ère pour les services laboratoires
En 1988, William Woodard et une équipe de spécialistes en biologie ont fondé Clinisys, animés par une passion commune pour l’amélioration des services de biologie grâce à des solutions logicielles particulièrement haut de gamme. Au fil des décennies, des opérations stratégiques ont permis à Clinisys de devenir le plus grand fournisseur de Systèmes d’Information de Laboratoire (LIS) en Europe.
Notre histoire : Aller toujours plus loin pour le laboratoire

1991 : Optimisation des services hospitaliers
Atlas a été fondée en 1991, rachetée par Roper en 2015 et fusionnée avec Sunquest en 2018, aux USA. Atlas a lancé une solution de proximité qui aide les hôpitaux à devenir plus productifs et rentables en accélérant les remboursements, en réduisant les radiations et les fuites de tests, et en améliorant les délais d’exécution des tests.
1992 : Innovation de rupture
En s’appuyant sur notre solide expertise en biologie dans le secteur privé, CliniSys a livré son premier système d’information de laboratoire (LIS) spécialisé au National Health Service (NHS) du Royaume-Uni.

1994 : Logiciel LIMS pour entreprises
La société de conseil en technologie ApolloLIMS a été fondée en 1994 et a rejoint la famille Clinisys en 2022. À l’origine connue sous le nom de Common Cents Systems, ApolloLIMS a lancé son LIMS de toxicologie en 1996 et son LIMS basé sur le cloud en 2012.

1998 : Création de Promium
La plus récente acquisition de Clinisys, Promium, a été fondée en 1998 et a rejoint la famille Clinisys en 2023. Initialement connue sous le nom de Cequel Systems, Promium a été créée pour fournir un support LIMS aux laboratoires environnementaux, d’eau et d’eaux usées.
Des leaders de l’industrie qui nous font avancer
Notre équipe de direction est composée d’experts chevronnés de l’industrie qui ont des dizaines d’années d’expérience dans l’édition de solutions logicielles pour laboratoire, dans le monde entier.
Notre parcours : Favoriser la croissance
Au cours des années qui ont suivi, nous avons établi de nombreux partenariats stratégiques, y compris une collaboration significative avec Siemens pour fournir des tests au point de service. Grâce à d’autres acquisitions stratégiques, nous avons étendu notre présence à travers l’Europe.

2000s : Croissance soutenue en Europe
Avec une base de clients substantielle dans les secteurs public et privé, CliniSys a acquis MIPS et Torex Laboratory Systems en 2005, devenant ainsi le plus grand fournisseur de LIS en Europe. MIPS a ensuite élargi son champ d’action en acquérant MCS-LDS en 2015 et Cointec en 2019.

2011 : Traçabilité renforcée
En 2011, nous avons lancé WorldCare, notre solution de gestion logistique, renforçant notre capacité à offrir une traçabilité complète des échantillons.

2012-2016 : Une série d’acquisitions stratégiques
Notre croissance s’accélère avec les acquisitions de Sunquest en 2012, Atlas en 2015, et Clinisys en 2016 par Roper Technologies.
S’adapter à une nouvelle ère
Aujourd’hui, Clinisys se focalise sur l’amélioration des résultats de santé et la sécurité de tous grâce à des innovations diagnostics et en technologies informatiques de laboratoire. Notre offre Clinisys Laboratory Solution (CLS), va au-delà du laboratoire médical et couvre neuf industries supplémentaires.

2020s : S’adapter aux nouveaux défis
Pour faire face à la pandémie de COVID-19, Clinisys a développé des solutions innovantes pour augmenter la capacité de tests à l’échelle nationale dans les principaux pays européens, répondant à une situation en permanente évolution. Plusieurs systèmes ont été adaptés pour soutenir les laboratoires et les unités de test mobiles pour la COVID-19.

2020s : Innovation permanente
Nous avons continué à innover, élargissant notre couverture fonctionnelle pour fournir des solutions pour le typage tissulaire et le dépistage pré et néo-natal.

Début 2022 : Début d’une nouvelle ère
Début 2022, Clinisys a acquis HORIZON Lab Systems et ApolloLIMS. Peu de temps après, Roper Technologies a fusionné Clinisys avec Sunquest, unissant cinq entreprises sous la marque Clinisys. Une autre acquisition de LIMS a suivi, avec l’intégration de Promium dans la famille Clinisys. En 2023, Clinisys a lancé la Clinisys Laboratory Solution (CLS) pour les industries scientifiques et continue de s’étendre à de nouveaux secteurs.

Aujourd’hui : Clinisys, votre partenaire de confiance
Les progrès rapides que nous avons réalisés grâce à nos différentes acquisitions et les nombreuses innovations que nous avons réalisées nous ont aidés à de devenir l’une des plus importantes sociétés dédiées aux diagnostics et à l’informatique de laboratoire au niveau international.

L’avenir : Croissance et innovation continues
Clinisys innove en continu pour exploiter les avantages de la technologie cloud, aux côtés de nos solutions éprouvées de premier ordre. Nous préparons nos clients à tirer parti des nouvelles technologies, telles que les solutions basées sur le cloud et l’avenir de GenAI. En 2025 et au-delà, CLS fera son entrée dans le secteur de la santé, avec un premier lancement aux États-Unis en 2025.
Nos valeurs
Clients
Nous prenons soin de nos clients – avec courage, sans réserve, avec notre meilleure volonté.
Simplicité
Une solution simple, c’est magnifique. Dans un univers où tout devient plus complexe, nous sommes fiers de viser chercher et d’atteindre l’excellence dans la simplicité.
Promesses
Nous les tenons. Les grandes et petites. Nous faisons de grandes promesses, et nous les tenons, chaque jour.
Travail d’équipe
Chacun de nous possède un potentiel immense, et en nous travaillant ensemble, nous créons l’opportunité extraordinaire de dépasser nos propres limites. Ensemble, nous pouvons accomplir de grandes choses et laisser une empreinte durable.